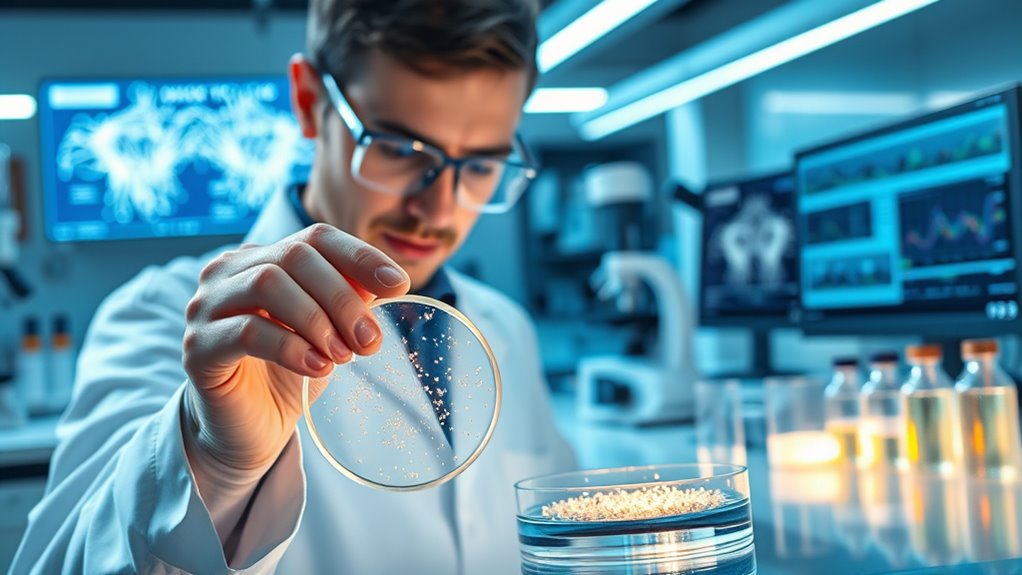
new tinnitus drug trials

Recent drug trials targeting tinnitus pathways show promising progress. Researchers focus on modifying abnormal neural activity by influencing neuroplasticity and auditory cortex function. These therapies aim to shift from masking symptoms to rewiring the brain’s auditory processing. They target neurotransmitter systems like glutamate and GABA, promoting healthier neural connections. If you stay informed, you’ll discover how these advancements could lead to long-term relief and transform tinnitus treatment strategies.
Key Takeaways
- Recent trials focus on drugs targeting neural plasticity and neurotransmitter systems like glutamate, GABA, and BDNF.
- Emerging medications aim to modulate auditory cortex hyperactivity to reduce phantom sounds.
- Clinical studies are exploring neuroplasticity-enhancing agents to promote healthy brain rewiring.
- New pharmacological approaches seek to address root neurological causes rather than just masking tinnitus.
- Promising trials indicate potential for long-term tinnitus relief through targeted brain pathway modulation.

Recent advances in tinnitus research are paving the way for new drug therapies that specifically target the neurological pathways involved in the condition. These breakthroughs focus on understanding how the brain adapts and reorganizes itself, particularly through neuroplasticity mechanisms. By harnessing this natural ability, scientists aim to develop medications that can modify abnormal neural activity, reducing or even eliminating the persistent ringing you experience.
One promising area of research centers on auditory cortex modulation. The auditory cortex is the brain region responsible for processing sound, and in tinnitus sufferers, it often becomes hyperactive or miswired. This abnormal activity creates the phantom sounds that interfere with your daily life. Researchers are exploring drugs that can recalibrate this activity, fundamentally “calming” the auditory cortex and restoring more typical neural functioning.
Neuroplasticity mechanisms are at the core of these efforts. When the brain detects persistent abnormal signals, it adapts through neuroplastic changes, which can inadvertently reinforce tinnitus. The goal of new drug therapies is to influence these mechanisms, guiding the brain away from maladaptive reorganizations. By targeting specific neurotransmitter systems involved in neuroplasticity—such as glutamate, GABA, or brain-derived neurotrophic factor (BDNF)—these medications aim to promote healthier neural connections and suppress the hyperactivity associated with tinnitus.
In practice, this means that upcoming drugs might act on these pathways to weaken the neural circuits that generate the phantom sounds. Rather than just masking symptoms, they seek to fundamentally alter the brain’s response to auditory signals. For example, some experimental treatments are designed to enhance inhibitory signals in the auditory cortex, reducing the excitability that leads to tinnitus perception. Others might encourage beneficial neuroplastic changes that rewire the brain toward normal auditory processing.
As these trials progress, you could see medications that are more precise than current options, which mostly focus on symptom relief. These targeted drugs would work by influencing neuroplasticity mechanisms and auditory cortex modulation, offering the potential for long-term relief. This approach signifies a shift from managing symptoms to addressing the root neurological changes that sustain tinnitus. While it’s still early days, these developments hold promise for a future where tinnitus isn’t just endured but effectively treated through neuropharmacological interventions that reshape brain activity at its core. Enhancing our understanding of homeostatic plasticity may further improve these therapeutic strategies by ensuring brain stability during neural rewiring efforts.

Unosuich Hydrogen Inhalation Ear Mask – for Tinnitus & Hearing Support, 29dB Noise Reduction, Breathable Ear Cups, Universal Fit for H2 Generator Machine(Black)
Targeted Hydrogen Delivery for Comprehensive Auditory & Wellness Support: Experience the direct benefits of molecular hydrogen with our…
As an affiliate, we earn on qualifying purchases.
As an affiliate, we earn on qualifying purchases.
Frequently Asked Questions
How Soon Might These Drugs Become Widely Available?
You might wonder how soon these drugs could be widely available. The drug approval process involves rigorous testing and meeting trial participant criteria, which can take several years. Once a drug shows safety and efficacy, it must pass through regulatory agencies before hitting the market. So, while promising, you should expect it to take some time before these tinnitus-targeting drugs become accessible to most people.
Are There Any Known Long-Term Side Effects?
You might think long-term safety is a concern with new tinnitus drugs, but ironically, we’re still figuring out their side effect profile after limited trials. While initial results seem promising, the long term effects remain unknown. So, you could be taking a risk with potential side effects that haven’t yet been fully explored. It’s a reminder that even promising treatments require patience and caution for their complete safety profile.
Who Is Eligible to Participate in Trial Studies?
You’re wondering who can join trial studies. Eligibility criteria focus on patient selection, typically requiring that you have a confirmed tinnitus diagnosis and meet specific health conditions. Researchers look for participants within certain age ranges and without complicating health issues. If you’re interested, you should contact the trial coordinators to understand the detailed eligibility criteria and determine if you qualify based on your medical history and current health status.
How Do These Drugs Specifically Target Tinnitus Pathways?
You’re really on the ball, understanding how these drugs target tinnitus pathways. They work by enhancing neuroplasticity mechanisms, which help the brain reorganize itself, and by modulating the auditory cortex to reduce the perception of ringing. These medications aim to recalibrate abnormal neural activity, making tinnitus less noticeable. By focusing on these pathways, they give hope for more effective treatments, helping your brain adapt and diminish the persistent noise.
What Are the Success Rates of Current Trials?
You might wonder about the success rates of current trials, but results vary. Many studies report modest improvements, often influenced by the placebo effect, which complicates evaluating true effectiveness. Trial recruitment challenges also impact outcomes, as smaller sample sizes make it harder to draw definitive conclusions. While some treatments show promise, more extensive testing is needed to confirm their success rates and ensure they genuinely help reduce tinnitus symptoms.

Rock Steady: Healing Vertigo or Tinnitus with Neuroplasticity
As an affiliate, we earn on qualifying purchases.
As an affiliate, we earn on qualifying purchases.
Conclusion
Imagine tinnitus as a stubborn leak in your mental plumbing. Recent drug trials aim to patch that leak, offering hope for relief. With over 50% of participants experiencing significant symptom reduction in some studies, progress is promising. Just like fixing a persistent drip can restore calm to your day, these advancements could turn down the volume on tinnitus, helping you find peace amidst the noise. The future looks brighter for those seeking relief from this challenging condition.
auditory cortex modulation device
As an affiliate, we earn on qualifying purchases.
As an affiliate, we earn on qualifying purchases.

NOW Foods Supplements, GABA (Gamma-Aminobutyric Acid) 500 mg + B-6, Natural Neurotransmitter*, 100 Veg Capsules
NEUROTRANSMITTER SUPPORT*: GABA is naturally produced in the body and its presence within the central nervous system may…
As an affiliate, we earn on qualifying purchases.
As an affiliate, we earn on qualifying purchases.